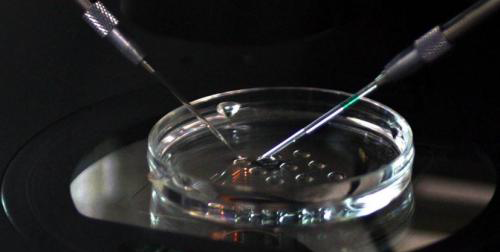

为什么香港试管婴儿费用会比内地贵2倍
- 试管婴儿
- 2023-04-22 09:11
香港试管婴儿费用高的原因
在内地单周期试管婴儿费用在3-4万元左右,而香港试管婴儿费用则在10万左右港币,折合人民币大概在8万左右,相比内地可能会贵2-3倍,造成如此价格差的原因不仅是因为成功率、技术上,好的医疗服务体系也是非常关键的一点。
香港单周期试管费用在9-10万左右,比内地高出2倍多
目前香港普遍采用的是第三代试管婴儿技术,同内地第二代试管婴儿相比是处于不同技术水平的,这也是造成香港试管婴儿医疗费用在9-10万的原因之一,具体收费差距如下:
1、在技术上内地主要以第一代、第二代试管婴儿技术为主,极少数的才被允许做第三代试管,而在香港以第三代试管为主,在成功率上香港要更高一些;
2、医疗环境上内地就医压力大,完全是流水线操作,从检查到移植周期很长,而香港基本是医生一对一治疗,医生非常的熟悉不同患者的身体情况,能够更好地制定个性化的试管方案,帮助提高成功率;
3、从实验室环境来说,内地针对胚胎检测不够精密,而在香港可对胚胎发育情况进行24小时实时检测,在筛查精子时还能放大6000倍以上来观察精子形态;
香港试管婴儿费用为什么这么贵
4、对比成功率,国内的试管婴儿平均成功率在20%-30%间,香港试管婴儿成功率高达65%左右,许多明星艺人如刘德华、朱丽倩、李嘉欣等都在香港通过试管婴儿助孕成功。
正因为香港做试管婴儿具备的这些优势,尽管单周期试管婴儿费用在10万元左右的情况下,也让很大一部分不孕患者选择到香港助孕。

发表评论